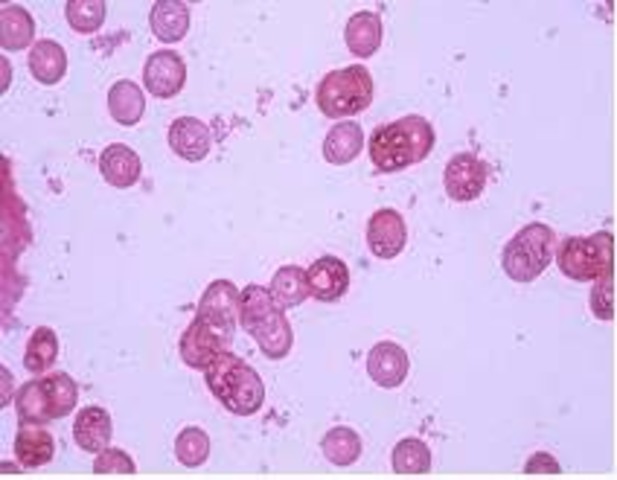
Haemophilus influenzae.

-
Dice que los germenes vivos pasan de un individuo a otro
-
Hooke descubrió las células observando en el microscopio una laminilla de corcho, dándose cuenta que estaba formada por pequeñas cavidades poliédricas que recordaban a las celdillas de un panal. Por ello cada cavidad se llamó célula.
En 1665 Hooke publicó Micrographia, un libro que describe sus microscópicas observaciones, y algunos trabajos originales en la biología. -
En 1674 realizó la primeradescripción precisa de losglóbulos rojosobservó en el agua de unestanque, el agua delluvia y la saliva humana,lo que él llamaríaanimáculos, conocidos enla actualidad comoprotozooarios.
-
Se dedicó a pulir lentes y a observar todos los tejidos que iba construyendo. Estudió granos de polen, fluidos corporales, sarro de los dientes, y vio unas pequeñas estructuras que podían moverse y las llamó animáculos.
-
Acaba con la idea de la generación espontánea (Experimento de Redi). Utiliza unos botes de cristal con trozos de carne, dichos botes los tapa con unas gasas que permiten el paso del aire pero de nada más, entonces no se generan "animáculos" en estos trozos de carne. La solución está en las larvas que son depositadas por moscas que se posaban en la carne, en los botes sin tapar, y hacían posible la aparición de esos "animáculos"
-
(1765-1775) Prolongando el periodo de calentamiento y sellando con más cuidado losrecipientes, Spallanzani pudo demostrar que dichos caldos no generabanmicroorganismos mientras los recipientes estuvieran sellados.
-
Estudia la resistencia a la viruela que presentaban ciertos grupos de población y comienza el desarrollo de técnicas de vacunación.
-
Asocia por primera vez la presencia de un hongo a una enfermedad (malasegno) presente en gusanos de seda.
-
Descubre un hongo (Phytophthora infestans) que produce la podredumbre de la patata.
-
Identifica por primera vez a un microorganismo (un hongo) como el agente etiológico de una enfermedad cutánea humana (pitiriasis versicolor).
-
John Snow realiza el primer estudio epidemiológico del cólera en Londres.
-
Devaine, observa por primera vez la presencia en la sangre de animales enfermos de un microorganismo patógeno, Bacillus anthracis.
-
Semmelweis, establece la etiología de las fiebres puerperales
-
Demuestra que hay animáculos en el aire, pasando un tubo con aire y un algodón en el medio impregnado de eter. Lo miraba al microscopio y veía organismos, pero en cambio cuando lo hacía con aire caliente no veía absolutamente nada.
Comenzó investigando los procesos de fermentación del vino y la cerveza y descubrió la existencia de las bacterias que interferían en este proceso. -
Lister, introduce la asepsia quirúrgica, pulverización fenol en las salas donde se intervenía quirúrgicamente.
-
Propuso la clasificación de las bacterias: género, especie y variedades.• Describió otros microorganismos patógenos transmitidos por agua contaminada, distintos al V.
-
Médico rural alemán que observó la presencia de microorganismos en la sangre de animales. Fue el primero que desarrolló o que aisló un microorganismo en cultivo puro. Postulados de Koch: Un microorganismo es el responsable de una enfermedad o de otro proceso cualquiera.
Postulado 1: El microorganismo debe estar presente en animales afectados y ausente en los sanos.
Postulado 2: El microorganismo debe ser aislado en un medio de cultivo puro.
Postulados 3 y 4: Este microorganismo que hemos -
Realiza los primeros estudios sobre los efectos geoquímicos producidos por bacterias.
-
Describen el agente causante de la glosopeda (fiebre aftosa): aislamiento de virus animales
-
Alexander Fleming descubre la penicilina
-
Fleming descubre el fenómeno de la antibiosis.
-
Desarrollo de la penicilina y otros agentes antibacterianos
-
Alfred Hershey y Martha Chase demuestran que el DNA era el material genético de algunos virus.
-
Heinz Ludwig Fraenkel-Conrat y Robley Williams demuestran que el RNA era el material genético del virus del mosaico del tabaco.
-
Las bacterias pueden tener cromosomas lineales.
-
Se secuencia el genoma de la bacteria Haemophilus influenzae.
-
Aparece en Asia la gripe aviar, producida por el subtipo H5N1 del virus Influenza A que puede transmitirse al hombre.
-
En México aparece un brote de gripe porcina, posteriormente llamada gripe A H1N1
-
Prusiner descubre los priones, agentes causantes de la encefalopatía espongiforme bovina y de la enfermedad de Creutzfeldt-Jakob.
-
Prusiner descubre los priones, agentes causantes de la encefalopatía espongiforme bovina y de la enfermedad de Creutzfeldt-Jakob.
Plan projects on a visual timeline
Map milestones, phases, deadlines, and key events in one place so the sequence is easier to see and share. Timetoast is a timeline maker for work, school, research, and stories.